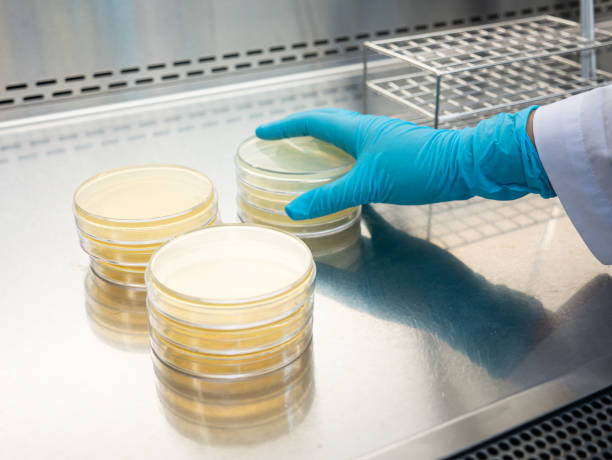

-
+962793844404
Sunday To Thursday
8:00AM - 5:00PM
-
Contact Us
+962793844404
-
Monodoze
Follow Us -
Monodoze
Follow Us -
Company
Needs More Deatils
-
Contact Us
Need More Details
-
Monodoze Synaptic-B Kids 5ml×20 Drinkable Liquid Sachet/Box
Regular price 0.000 JODRegular priceUnit price / per -
Monodoze Synaptic-B 10ml×10 Drinkable Liquid Sachet/Box
Regular price 0.000 JODRegular priceUnit price / per -
Monodoze Oxiron Kids 5ml×20 Drinkable Liquid Sachet/Box
Regular price 0.000 JODRegular priceUnit price / per -
Monodoze Oxiron 5ml×20 Drinkable Liquid Sachet/Box
Regular price 0.000 JODRegular priceUnit price / per -
Monodoze L-Carnitine 10ml×20 Drinkable Liquid Sachet/Box
Regular price 0.000 JODRegular priceUnit price / per -
Monodoze Cranberry 8ml×10 Drinkable Liquid Sachet/Box
Regular price 0.000 JODRegular priceUnit price / per -
Monodoze Collagen Joint 10ml×10 Drinkable Liquid Sachet/Box
Regular price 0.000 JODRegular priceUnit price / per